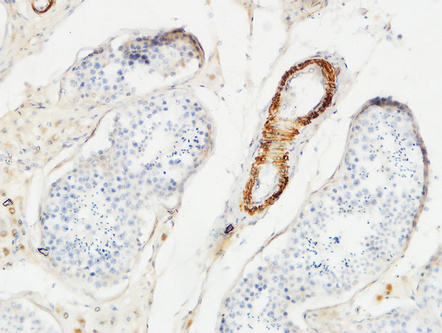

|
Immunofluorescence analysis of human-uterus tissue. 1,Actin β Polyclonal Antibody(red) was diluted at 1:200(4°C,overnight). 2, Cy3 labled Secondary antibody was diluted at 1:300(room temperature, 50min).3, Picture B: DAPI(blue) 10min. Picture A:Target. Picture B: DAPI. Picture C: merge of A+B |
 |
Immunofluorescence analysis of rat-lung tissue. 1,Actin β Polyclonal Antibody(red) was diluted at 1:200(4°C,overnight). 2, Cy3 labled Secondary antibody was diluted at 1:300(room temperature, 50min).3, Picture B: DAPI(blue) 10min. Picture A:Target. Picture B: DAPI. Picture C: merge of A+B |
 |
Western Blot analysis of 1,hela 2,A549 3,HEPG2 4,Mouse-brain 5,Mouse-lung 6,Mouse-liver 7,Rat-brain 8,Rat-lung 9,Rat-liver cells using primary antibody diluted at 1:1000(4°C overnight). Secondary antibody:Goat Anti-rabbit IgG IRDye 800( diluted at 1:5000, 25°C, 1 hour). Cell lysate was extracted by Minute™ Plasma Membrane Protein Isolation and Cell Fractionation Kit. |
 |
Immunohistochemical analysis of paraffin-embedded Human-uterus tissue. 1,Actin β Polyclonal Antibody was diluted at 1:200(4°C,overnight). 2, Sodium citrate pH 6.0 was used for antibody retrieval(>98°C,20min). 3,Secondary antibody was diluted at 1:200(room tempeRature, 30min). Negative control was used by secondary antibody only. |
 |
Immunohistochemical analysis of paraffin-embedded Human-uterus-cancer tissue. 1,Actin β Polyclonal Antibody was diluted at 1:200(4°C,overnight). 2, Sodium citrate pH 6.0 was used for antibody retrieval(>98°C,20min). 3,Secondary antibody was diluted at 1:200(room tempeRature, 30min). Negative control was used by secondary antibody only. |
 |
Immunohistochemical analysis of paraffin-embedded Human-colon tissue. 1,Actin β Polyclonal Antibody was diluted at 1:200(4°C,overnight). 2, Sodium citrate pH 6.0 was used for antibody retrieval(>98°C,20min). 3,Secondary antibody was diluted at 1:200(room tempeRature, 30min). Negative control was used by secondary antibody only. |
 |
Immunohistochemical analysis of paraffin-embedded Human-liver-cancer tissue. 1,Actin β Polyclonal Antibody was diluted at 1:200(4°C,overnight). 2, Sodium citrate pH 6.0 was used for antibody retrieval(>98°C,20min). 3,Secondary antibody was diluted at 1:200(room tempeRature, 30min). Negative control was used by secondary antibody only. |
 |
Immunohistochemical analysis of paraffin-embedded Human-uterus-cancer tissue. 1,Actin β Polyclonal Antibody was diluted at 1:200(4°C,overnight). 2, Sodium citrate pH 6.0 was used for antibody retrieval(>98°C,20min). 3,Secondary antibody was diluted at 1:200(room tempeRature, 30min). Negative control was used by secondary antibody only. |
 |
Immunohistochemical analysis of paraffin-embedded Human-stomach-cancer tissue. 1,Actin β Polyclonal Antibody was diluted at 1:200(4°C,overnight). 2, Sodium citrate pH 6.0 was used for antibody retrieval(>98°C,20min). 3,Secondary antibody was diluted at 1:200(room tempeRature, 30min). Negative control was used by secondary antibody only. |
 |
Immunohistochemical analysis of paraffin-embedded Rat-kidney tissue. 1,Actin β Polyclonal Antibody was diluted at 1:200(4°C,overnight). 2, Sodium citrate pH 6.0 was used for antibody retrieval(>98°C,20min). 3,Secondary antibody was diluted at 1:200(room tempeRature, 30min). Negative control was used by secondary antibody only. |
 |
Immunohistochemical analysis of paraffin-embedded Mouse-heart tissue. 1,Actin β Polyclonal Antibody was diluted at 1:200(4°C,overnight). 2, Sodium citrate pH 6.0 was used for antibody retrieval(>98°C,20min). 3,Secondary antibody was diluted at 1:200(room tempeRature, 30min). Negative control was used by secondary antibody only. |
 |
Immunohistochemical analysis of paraffin-embedded Mouse-lung tissue. 1,Actin β Polyclonal Antibody was diluted at 1:200(4°C,overnight). 2, Sodium citrate pH 6.0 was used for antibody retrieval(>98°C,20min). 3,Secondary antibody was diluted at 1:200(room tempeRature, 30min). Negative control was used by secondary antibody only. |
 |
Immunohistochemical analysis of paraffin-embedded Mouse-spleen tissue. 1,Actin β Polyclonal Antibody was diluted at 1:200(4°C,overnight). 2, Sodium citrate pH 6.0 was used for antibody retrieval(>98°C,20min). 3,Secondary antibody was diluted at 1:200(room tempeRature, 30min). Negative control was used by secondary antibody only. |
|
Immunohistochemical analysis of paraffin-embedded Human testis. 1, Antibody was diluted at 1:100(4° overnight). 2, High-pressure and temperature EDTA, pH8.0 was used for antigen retrieval. 3,Secondary antibody was diluted at 1:200(room temperature, 30min). |
 |
Aikeqing, a kidney- and spleen-tonifying compound Chinese medicine granule, prevented ovariectomy-induced bone loss in rats via the suppression of osteoclastogenesis. BIOMEDICINE & PHARMACOTHERAPY Xiao-Ling Shen WB Rat,Mouse left femurs bone marrow macrophages (BMMs) |